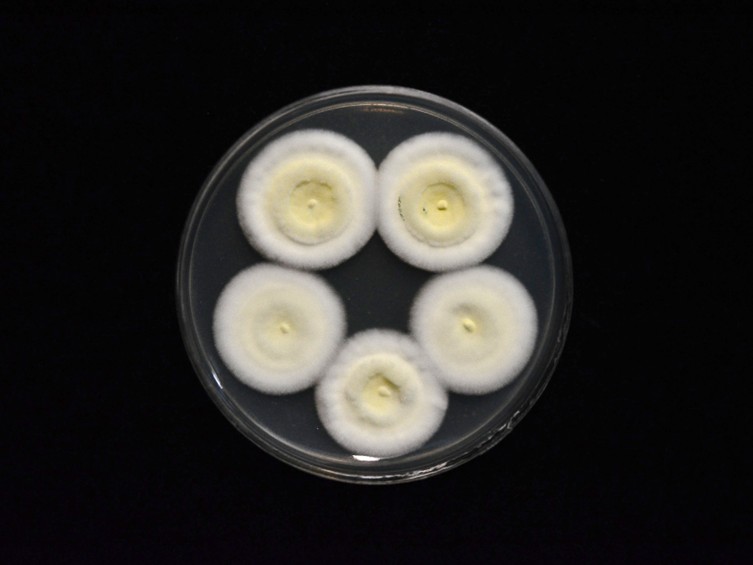

Holotype:
BRAZIL, Bacupari Reserve, Cavalcante, Goias, 4 Feb. 2015, C. Montalva, holotype UFG 49886, ex-type living culture ARSEF 12850 (= IP 414).
Habitat:
Underside of dicotyledonous leaves.
Host:
Ectobiidae (Blattodea).
Description:
 Host’s head and thorax covered with pale green mycelium and by sporulating conidiophores.
Host’s head and thorax covered with pale green mycelium and by sporulating conidiophores.  Phialides ellipsoidal to cylindrical with semi-papillate apices, 5–10 × 2–3 μm.
Phialides ellipsoidal to cylindrical with semi-papillate apices, 5–10 × 2–3 μm.  Conidia smooth-walled, green, ellipsoidal to cylindrical, 5–10 × 2–4 μm.
Conidia smooth-walled, green, ellipsoidal to cylindrical, 5–10 × 2–4 μm.
Culture characteristics:
Colonies on PDA attaining a diam of 20–22 mm in 14 d, white to pale yellow, abundant aerial mycelium, fluffy, entire edge, poor sporulation with dark green
PDA attaining a diam of 20–22 mm in 14 d, white to pale yellow, abundant aerial mycelium, fluffy, entire edge, poor sporulation with dark green  conidia produced on aerial mycelium. Sporulation starts at 12 d after inoculation, reverse uncolored. Conidiophores terminating in branches, with 1–4
conidia produced on aerial mycelium. Sporulation starts at 12 d after inoculation, reverse uncolored. Conidiophores terminating in branches, with 1–4  phialides per branch. Phialides ellipsoidal to cylindrical with semi-papillate apices, 5–10 × 2–3 μm. Conidia smooth-walled, dark green, ellipsoidal to cylindrical with rounded apices, 6–8 × 2–3 μm.
phialides per branch. Phialides ellipsoidal to cylindrical with semi-papillate apices, 5–10 × 2–3 μm. Conidia smooth-walled, dark green, ellipsoidal to cylindrical with rounded apices, 6–8 × 2–3 μm.
Reference:
Montalva C, Collier K, Rocha LF, et al. (2016). A natural fungal infection of a sylvatic cockroach with Metarhizium blattodeae sp. nov., a member of the M. flavoviride species complex. Fungal biology 120: 655–665.
DOI: https://doi.org/10.1016/j.funbio.2016.03.004Species |
Strain |
Compound |
Pubchem CID |
Biological activity |
Reference |
|---|
|
Strain |
- |
|---|---|
| BCC 20255 | - |